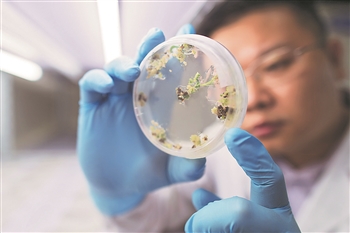

庆祝中国共产党成立100周年特刊
【奋斗百年路 启航新征程 东方潮】从六间厂房到“中国光谷”
①

②

③

④

⑤

光谷地标——位于武汉未来科技城的“马蹄莲”大楼。
题记
在武汉,一束光穿越33年时光,在一片荒野之上,孕育出一个超级产业。
从24平方公里到518平方公里,从零到10万多家企业、52家上市公司、80余家“第二总部”……
这就是“中国光谷”,自从33年前那一束光照亮这块荒野之地,科技、创新就成了它直击长空的两翼。
国际化“创新光谷”、现代化“富强光谷”、生态化“美丽光谷”——“中国光谷”正开足马力,向更高远的目标奋进。
长江右岸,武汉东郊。上世纪70年代,这里尚是一片荒野之地,因距主城区较远,一度被视为武汉建成区“地图外两厘米”的地方。
33年前,正是在这里,诞生了东湖新技术创业者中心。1部电话、6间厂房、600多平方米……这便是新中国第一家科技企业孵化器的全部家当。
很多人不曾想到,33年弹指一挥间,从我国第一根光纤、第一个光通信国际标准,到我国第一家科技企业孵化器、第一款商用存储芯片、第一个400G硅光模块、全球首款128层三维闪存芯片、全球首个超高通量“火眼”实验室……一大批高技术核心产业在长江岸边蓬勃生长。
6间厂房居然孕育出了518平方公里的创新产业区。当年的东湖新技术创业者中心蜕变为东湖高新区,被誉为“中国光谷”。33年的发展历程,犹如一部波澜壮阔的史诗,涌现出诸多感人至深的创业故事和锐意创新的风流人物。
一根“小光纤”,牵起追光路
光纤通信,曾被评为“二战以来最有意义的四大发明之一”。光纤通信是以光波作为信息载体、以光纤作为传输媒介的一种通信方式,在现代电信网中起着举足轻重的作用。如果没有光纤通信,就不会有今天的互联网和通信网络。
1973年,时任武汉邮电科学研究院二室副主任的赵梓森提出发展光纤通信。但当时的中国,对外交流与开放程度较低,搞光纤在当时很多专家看来是“天方夜谭”。
一无资金,二无资料和设备,三无实验室,赵梓森多方游说,把单位办公楼一楼清洗间改造成一间实验室,找来年轻同事帮忙,自制设备“土法上马”,一年多的时间里重复数千次试验,造出了一台光纤拉丝机。
1976年3月,赵梓森团队拉出一根7米长的玻璃细丝,这是具有中国自主知识产权的第一根实用光纤,大大缩短了我国在光通信领域与发达国家的差距。1982年,赵梓森在武汉实现了中国的首次光纤通话。中国信息产业革命的大幕,由此揭开。
这根“小光纤”,不但实现了我国自主创新的光纤通信变革,而且也开启了东湖高新区30多年的追光之路。
1983年底,前去上海取经的武汉市政府一位同志无意中听到消息:两个月前,国务院召集京津沪穗等城市研讨“新技术革命”。武汉科研院所密集,人才荟萃,“新技术革命”怎能没有武汉?
1984年春节后,当时的武汉市咨询委员会组织了一系列“新技术革命”对策研讨会,决定主动到国务院去申请立项,最后形成《关于在武汉建立激光工业、光纤通信、生物工程三个基地和信息中心的建议》,上报中央。
3个月后,喜讯传来,国务院办公厅《关于印发〈新的技术革命与我国对策研究的汇报提纲〉的通知》写明,在武汉等全国13个城市试办新兴技术新兴产业密集的小经济区。同时,集中力量建设京津、上海、武汉3个(光导纤维通信技术)开发中心。
武汉,终于在应对世界新技术革命的国家策略中“排上了队”!
1988年,武汉东湖高新区建设上马提速。
接下来的30多年里,在这片土地上,以余少华、庄丹为代表的中国第二代“追光者”,把赵梓森拉出的这根光纤做成了湖北最具竞争力的通信光纤产业。烽火科技、长飞光纤,成为武汉高新技术产业的代表。湖北光纤产业规模跃居世界第一。
2018年,武汉邮科院研发的光纤,一根可实现67.5亿对人同时通话。中国成为继美国、日本后世界第三大光通信技术强国。我国的光纤通信用品产量和市场占有率已是世界第一。
2000年5月,赵梓森等26位院士和专家,在《关于加快技术创新,发展我国光电子信息产业的建议》上签名,吁请党中央、国务院批准武汉建设国家级光电子信息产业基地——“中国光谷”。次年2月28日,科技部批准了这一建议。
“武汉·中国光谷”由此而来。
把技术从实验室“赶”出来
如果说,当年的一束光照亮了这块荒野之地,那么,锚定高新技术项目,自主创新、干事创业的精神气质,从一开始便融入了光谷的成长“基因”中。
“没有解放思想,没有敢闯敢试,就没有光谷现在的局面。”回望走过的路,已退休的李复鸣不禁感慨。作为“小区办”最初的5人之一,李复鸣25岁离开武汉市政府办公厅来到“小区办”,一直干到退休,是东湖新技术开发区建设全程见证者之一。
“小区办”成立了,缺人、缺钱、缺地,唯独不缺“逢山开路,遇水架桥”的改革胆略和勇气。“面向全社会公开招聘!”录取23人,800多人应聘。报名者中,来了中船722研究所副总工程师侯汉屏。
这群朝气蓬勃的年轻人,除了规划“小区”未来,另一项重要工作就是游说手上握着科技成果的院所知识分子“下海”创办企业。在上世纪80年代的武汉,虽然高校、科研院所集聚,但“新技术难走出实验室”“科研与经济两张皮”现象,一度制约着城市发展。在“小区办”的努力下,一个个“吃螃蟹者”走出“院门”来到“小区”,其中就有龚伟——全国第一家孵化器的开创者。
1987年,东湖新技术开发区创办起全国第一家为下海科技人员服务的孵化器“东湖新技术创业者中心”。这里不仅提供场地、帮办执照,还用国家科委下拨的70万元扶助资金作担保,向银行贷款210万元,大胆投资在孵企业。
敢闯“无人区”,不断突破,已成为东湖新技术开发区的重要“基因”。
惟楚有材,唯才是用
2020年6月,国外某大学电子信息工程专业硕士毕业的武汉人郭坚,辞去境外一家世界500强企业算法工程师的工作,入职位于光谷的国家知识产权局专利局专利审查协作湖北中心。“希望尽快成为一名优秀的专利审查员,推动更多原始创新、自主可控技术创新发生在光谷。”郭坚说。
据统计,2020年,光谷新增留汉大学生9.52万人。而在约10年前,武汉这座拥有百万在校大学生的城市,还经历着“留人之痛”。大学生毕业后,往往首选北上广深等一线城市。如今,伴随光谷新兴产业的发展壮大,越来越多的大学生选择在光谷干事创业。
吸引青年人才,离不开不断攀升的经济实力。2019年,东湖新技术开发区经济总量在武汉市各行政区(功能区)排名第一;2020年,面对封控时间长、重启时间晚、疫情影响大等困难,“中国光谷”疫后迅速复苏,出台系列扶持企业优惠政策,加快推进重点项目建设,主要经济指标实现“深V反转”,全年GDP逆势增长5.1%,率先迈上2000亿元台阶,继续领跑全市,成为湖北省、武汉市疫后重振的一面旗帜。
集聚人才优势,更离不开突破体制机制坚冰。2012年,武汉石破天惊,发布“黄金十条”,在全国率先提出科技成果转化收益“三七开”:70%归研发团队,打破了国家对科技成果转化处置权的限制。2015年,湖北省人大常委会审议通过《东湖国家自主创新示范区条例》,首次通过立法引领推动自主创新示范区改革创新。2017年,东湖新技术开发区再推“新黄金十条”,率先推行“三权”改革,重点瞄准更为敏感的“成果所有权”,为科技成果“所有权”确权——教师可与高校共享职务成果所有权。2021年,武汉东湖新技术开发区发布“硬核科技十条”,为“硬核科技”企业人才引进、研发投入、场景示范等提供强有力支持。
制度创新,持续优化企业外部发展环境,成为“中国光谷”创新发展的重要催化剂。2020年,全年新增市场主体2万家、企业1.8万家,市场主体总数超过14万家。如今,数以万计的高层次人才,让“中国光谷”“每天不一样”。
迈向更高远目标
33年,始终有一股敢闯敢拼的劲头,这是“中国光谷”高质量发展的成功密码。
当年,凭借这一发展密码,武汉拯救了当时差点被扼杀在摇篮中的我国光纤产业。1988年,邮电部、武汉市与荷兰飞利浦公司共同创建长飞光纤光缆有限公司。不久,外商对华倾销光纤,长飞陷入低谷。外方股东提议中止长飞。
看准了光纤通信的未来,武汉方面态度坚决:外方如撤出,武汉市联合邮电部接手!同时,支持邮科院自主研发光纤,将武汉市的单晶硅厂基本无偿转让给邮科院,用来生产光纤光缆——这才有了如今烽火科技携手长飞,使武汉成为世界最大光纤生产基地,将中国信息“神经”牢牢掌握在自己手中的格局。
2008年11月,武汉东南的二妃山下,光谷生物城奠基。当时,有人质疑:“金融危机寒流弥漫,生物城能搞起来?”东湖高新区顶住压力,“放眼全球,生物是继信息产业之后最大潜力股!”
13年过去了,光谷生物城不仅活了下来,还走在了全国生物产业基地前列,跃上了世界舞台,发展出即将突破2000亿元的大产业。
随着数字经济浪潮袭来,“中国光谷”以数字与产业互为支撑,形成了独特的“第二总部”现象。短短几年,小米、科大讯飞、小红书等80多家互联网领军企业在这里设立“第二总部”,新增中高端就业岗位数万个。在光电子信息、生物医药等领域,华星光电、华为、华大基因、联影医疗等数十家企业,也将区域总部或“第二总部”落子“中国光谷”。
如今,这里拥有13家工研院、68家孵化器、108家众创空间;在企博士超过1万人、硕士6万余人、本科学历近30万人;本科及以上学历从业人员占比64.5%,在全国10家重点建设的“世界一流高科技园区”中位列第一。这里更是享誉世界的现代化科技新城和宜业宜居之城。
2021年2月,《光谷科技创新大走廊核心承载区总体发展规划》正式发布,为光谷未来30年创新发展描绘了蓝图。核心区建设同步启动,将以“光谷科技创新大走廊”为纽带,形成拉动武汉、鄂州、黄石、黄冈、咸宁协同发展的湖北全域创新格局。
最近两年,5G、新零售、在线教育、人工智能、数字文娱、工业互联网、智慧城市、云计算等数字经济产业蓬勃发展。“中国光谷”迎来时代新机遇!
责任编辑:韩韫超
图①:生物产业进驻光谷。
图②:烽火科技实验室。
图③④:武汉光博会上亮相的“尖板眼”产品。
图⑤:光谷政务服务中心业务办理现场。
本版照片均由受访者提供



×